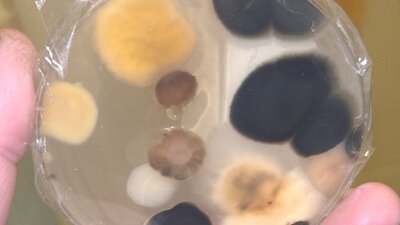

Indiana Needs Mold Safety Laws Now — Protect Families from Toxic Exposure

Indiana Needs Mold Safety Laws Now — Protect Families from Toxic Exposure
The Issue
My name is Kristy Litch, and I live in Sellersburg, Indiana. Toxic mold has taken nearly everything from me. It destroyed my health, my finances, and my home — and now I’m fighting for my freedom because of it.
I’ve slept in my car. I’ve spent six months in a hotel trying to survive. My father, an Air Force veteran already battling liver failure, was exposed and began vomiting blood. I’ve been to urgent care repeatedly with severe infections and lupus flare-ups, even struggling to breathe.
And still, the health department told me there’s nothing they can do, because Indiana has no enforceable laws to protect families from mold exposure.
I lost my savings, my furniture, and even my grandmother’s belongings — all destroyed by black mold. Now I’m in another home already taken over by mold, and when I showed my landlord proof, he told me I “just needed to move.” With what? I’ve already lost everything.
I’m also trying to come up with $6,000 to fight false criminal charges after police mistook my mold-related illness for drug use. That’s how bad this has gotten — people are getting sick, losing their homes, and being criminalized for being victims.
This petition calls on Indiana lawmakers to:
Establish enforceable mold safety laws to protect tenants and homeowners.
Require landlords to remediate unsafe mold conditions and disclose any history of contamination before renting or selling.
Create funding or assistance programs for people forced out of their homes due to mold-related illness.
Recognize mold exposure as a serious health issue, not a cosmetic one.
No one should have to lose their home, health, and dignity — or risk jail — because the state refuses to act.
Please sign and share this petition to demand that Indiana legislators finally take action to protect families, veterans, and children from the devastating effects of toxic mold.
Together, we can make sure no one else has to live — or die — this way.

25
The Issue
My name is Kristy Litch, and I live in Sellersburg, Indiana. Toxic mold has taken nearly everything from me. It destroyed my health, my finances, and my home — and now I’m fighting for my freedom because of it.
I’ve slept in my car. I’ve spent six months in a hotel trying to survive. My father, an Air Force veteran already battling liver failure, was exposed and began vomiting blood. I’ve been to urgent care repeatedly with severe infections and lupus flare-ups, even struggling to breathe.
And still, the health department told me there’s nothing they can do, because Indiana has no enforceable laws to protect families from mold exposure.
I lost my savings, my furniture, and even my grandmother’s belongings — all destroyed by black mold. Now I’m in another home already taken over by mold, and when I showed my landlord proof, he told me I “just needed to move.” With what? I’ve already lost everything.
I’m also trying to come up with $6,000 to fight false criminal charges after police mistook my mold-related illness for drug use. That’s how bad this has gotten — people are getting sick, losing their homes, and being criminalized for being victims.
This petition calls on Indiana lawmakers to:
Establish enforceable mold safety laws to protect tenants and homeowners.
Require landlords to remediate unsafe mold conditions and disclose any history of contamination before renting or selling.
Create funding or assistance programs for people forced out of their homes due to mold-related illness.
Recognize mold exposure as a serious health issue, not a cosmetic one.
No one should have to lose their home, health, and dignity — or risk jail — because the state refuses to act.
Please sign and share this petition to demand that Indiana legislators finally take action to protect families, veterans, and children from the devastating effects of toxic mold.
Together, we can make sure no one else has to live — or die — this way.

25
The Decision Makers

Petition Updates
Share this petition
Petition created on November 30, 2025

